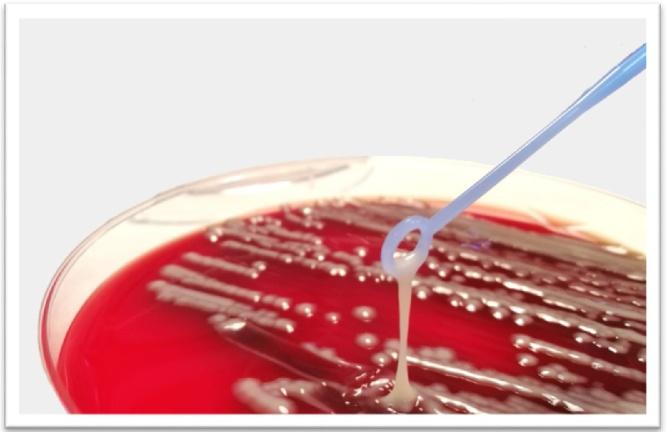
https://cdn.ncbi.nlm.nih.gov/pmc/blobs/a0bb/6514362/7f5d3333d474/gr1.jpg

高黏液黏稠度:社区获得性感染中的一项挑战。
Hypermucoviscous : A challenge in community acquired infection.
作者信息
Sánchez-López Javier, García-Caballero Andrea, Navarro-San Francisco Carolina, Quereda Carmen, Ruiz-Garbajosa Patricia, Navas Enrique, Dronda Fernando, Morosini María Isabel, Cantón Rafael, Diez-Aguilar María
机构信息
Servicio de Microbiología, Hospital Universitario Ramón y Cajal and Instituto Ramón y Cajal de Investigación Sanitaria (IRYCIS), Madrid, Spain.
Red Española de Investigación en Patología Infecciosa (REIPI), Instituto de Salud Carlos III, Madrid, Spain.
出版信息
IDCases. 2019 May 3;17:e00547. doi: 10.1016/j.idcr.2019.e00547. eCollection 2019.
In 1986, a new syndrome was described in Taiwan secondary to hypervirulent (hvKP), and its main feature was the ability to cause severe infection in young and immunocompetent hosts. Their virulence is explained by the efficient acquisition of iron and an increase in capsule production, which confer the characteristic hypermucoviscous phenotype. Most of these cases have been described in Asia and subsequently spread to America and Europe, where their prevalence is much lower. We present four cases of bacteremia and liver abscesses secondary to hypervirulent two of them associated with endophthalmitis isolates recovered from two of the patients belonged to capsular serotype K1 (genes and ), while the other two were K2 (gene ). Both of the K1 isolates were classified into a ST23, and isolates of serotype K2 belonged to the ST375 and ST881 clones. In Europe, hvKP isolates are less frequently recovered, mostly associated with Asian citizens or travelers, which was not the case in our patients. K1 capsular serotype is a major cause of primary liver abscess and secondary septic embolus, and K2 is associated with secondary liver abscess. Although these hypervirulent variants usually affect immunocompetent patients as in our cases, diabetes mellitus is a major risk factor for the most invasive cases, with concomitant poor prognosis. Identification of hypervirulent serotypes K1 and K2 should be considered as part of the microbiological diagnosis of community-acquired liver abscess due to their clinical implications.
1986年,台湾地区描述了一种继发于高毒力肺炎克雷伯菌(hvKP)的新综合征,其主要特征是能够在年轻且免疫功能正常的宿主中引起严重感染。它们的毒力可通过有效获取铁和增加荚膜产生来解释,这赋予了特征性的高黏液性表型。这些病例大多在亚洲被描述,随后传播到美洲和欧洲,在那里它们的患病率要低得多。我们报告了4例继发于高毒力肺炎克雷伯菌的菌血症和肝脓肿病例,其中2例与眼内炎有关。从2例患者中分离出的菌株属于荚膜血清型K1(基因 和 ),而另外2例是K2(基因 )。2株K1分离株均被分类为ST23,血清型K2的分离株属于ST375和ST881克隆。在欧洲,hvKP分离株较少被分离到,大多与亚洲公民或旅行者有关,而我们的患者并非如此。K1荚膜血清型是原发性肝脓肿和继发性脓毒性栓子的主要原因,K2与继发性肝脓肿有关。尽管这些高毒力变体通常像我们的病例一样影响免疫功能正常的患者,但糖尿病是大多数侵袭性病例的主要危险因素,预后较差。鉴于其临床意义,在社区获得性肝脓肿的微生物诊断中应考虑鉴定高毒力肺炎克雷伯菌的K1和K2血清型。